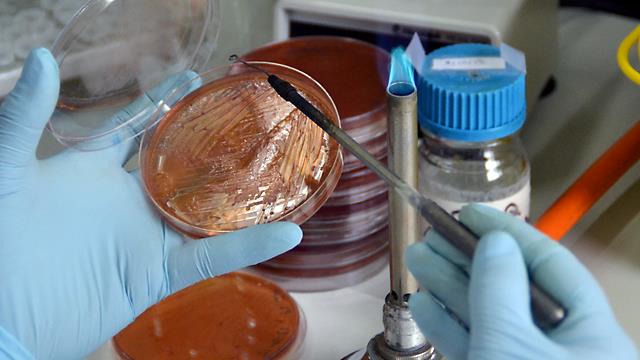

¿En quién piensas cuando piensas en la personificación de la ciencia?
A ver si hemos acertado: En un hombre, blanco, del hemisferio norte, de mediana edad y moderadamente rico. Si hemos acertado, te proponemos otro juego. Cierra los ojos, y piensa en una mujer científica… ¿Marie Curie?
A ver si hemos acertado: En un hombre, blanco, del hemisferio norte, de mediana edad y moderadamente rico. Si hemos acertado, te proponemos otro juego. Cierra los ojos, y piensa en una mujer científica… ¿Marie Curie?
Con juegos sencillos como estos, que no tienen nada de juego, comenzó su charla la profesora de la Facultad de Ciencia y Tecnología de la Universidad del País Vasco Marta Macho en las jornadas “Latinoamericanas en Ciencia y Salud”.
El pasado viernes 16 de octubre, la Sala de Juntas de la Facultad de Medicina y Odontología de la UPV/EHU fue el escenario en el que profesionales de distintas ramas de la salud y de la ciencia ofrecieron sus reflexiones y pusieron en común las experiencias de las mujeres que ejercen la medicina en Latinoamérica, así como el papel de la mujer en la historia de la medicina y en la divulgación científica.
La jornada Latinoamericanas en Ciencia y Salud organizada por la Facultad de Medicina y Odontología, el Foro Emakumeak Medikuntzan y la Dirección para la Igualdad de la UPV/EHU, comenzó con el saludo del Sr. Decano de la facultad, Enrique Hilario Rodriguez, y de las organizadoras: la profesora Lucía Gallego, componente del Foro Emakumeak Medikuntzan de la Facultad de Medicina y Odontología desde su fundación y responsable del Laboratorio de Antibióticos y Bacteriología Molecular, y Antonia Álvarez Díaz, profesora titular del Departamento de Biología Celular e Histología, secretaria académica y miembro de la Comisión de Igualdad del centro así como de Emakumeak Medikuntzan.
Reivindicando a las mujeres en ciencia
Una investigación mundialmente conocida sobre los prejuicios contra el género femenino en la ciencia es el caso de Jennifer y John, publicado en Pnas. Investigaciones más recientes, de este mismo año, abundan en la creciente evidencia de un sesgo de género contra las mujeres en la ciencia, la tecnología, la ingeniería, o las matemáticas que contribuiría a la subrepresentación de la mujer en esos campos.
Otros casos, como el de bióloga evolucionista Fiona Ingleby, las palabas del Nobel de fisiología o medicina en 2001, Tim Hunt sobre las mujeres en los laboratorios por las que tuvo que dimitir, o la constatación de la diferencia en el número de entradas sobre hombres y mujeres científicas en las enciclopedias digitales, fueron otros de los casos desarrollados por Marta Macho.
Montserrat Cabré, profesora de historia de la ciencia en la Facultad de Medicina de la Universidad de Cantabria disertó sobre la importancia de la historia. Según aseguró, la práctica médica de las mujeres y su incorporación a esta disciplina sufrió un revés con la fundación de las primeras universidades en Europa entre los siglos XII y XV: “La fundación de las universidades significó un retroceso para las mujeres porque se amplió la brecha con los varones ante la falta de presencia femenina en las aulas. El modelo masculino se apropió de los saberes, conocimientos y prácticas clínicas. La universidad se constituyó en una homosociedad estrictamente varonil y empezó a establecer quién podía ser médico legalmente basando sus títulos en la tradición de los clásicos, desde Hipócrates en adelante, borrando las aportaciones femeninas y apoyados en genealogías”.
Cabré citó también a Mary Putnam Jacobi, doblemente licenciada en medicina, quien en 1882 escribía que “es difícil explicarse este especial ensañamiento contra la admisión de las mujeres a la medicina sobre todo si se recuerda que esta admisión no es ninguna novedad ni ninguna innovación. Las mujeres ejercieron la medicina mientras la práctica de la medicina fue libre y mientras la entrada a la profesión se decidía exclusivamente por el gusto natural en tratar a los enfermos y cuidar sus dolencias”.
Otra de las autoras citadas en la conferencia de Cabré fue Kate Campbell Hurd-Mead. Según la conferenciante, en su alocución en la cena de médicas-autoras de 1936 auspiciada por la Medical Women´s National Association, Hurd-Mead pronunció un discurso en el que denunciaba que no todos los libros clásicos de medicina atribuidos a varones pueden considerarse como tal. Según Hurd-Mead “los llamados libros hipocráticos no fueron todos escritos por el padre de la medicina, probablemente ni tan siquiera el famoso juramento, ni escribió Hipócrates los libros de ginecología para sus discípulos. Estos libros llevan la impronta de los escritos de mujeres y fueron copiados durante siglos con el nombre de él”.
Ensayos clínicos
Cerró las sesiones antes del descanso de la mañana el profesor Javier Ballesteros de la UPV/EHU quien habló de las diferencias de género en la evaluación de tratamientos.
Ballesteros recordó que en los ensayos clínicos de fase III, en los que se valora la eficacia y la seguridad de un fármaco, se establecen una serie de condiciones de exclusión para quienes participan en el proceso de validación, entre las que están que las mujeres tomen métodos anticonceptivos suficientemente seguros o no vayan a quedarse embarazadas durante el transcurso del estudio. “Así, lo que en principio es una salvaguarda, se convierte en un problema porque también hay mujeres embarazadas que toman estas medicaciones, con lo que no sabemos muy bien, ni tenemos datos, para valorar la eficacia en la seguridad en estas situaciones”. Ballesteros fue incluso más allá al recordar que en las fases I y II participan muchas menos mujeres que varones.
Finalmente aseguró que la generalización de los datos obtenidos en estos estudios es discutible también, no sólo por el factor género, sino también por el factor edad, porque los participantes suelen ser varones de entre 20 y 30 años, con lo que el rango de edades de los potenciales consumidores, mucho mayor, no queda cubierto.
Las sesiones vespertinas de la jornada incluyeron conferencias de la profesora Zulema Bustamante, de la Facultad de Bioquímica y Farmacia de la Universidad Mayor de San Simón, Cochabamba (Bolivia), a quien puede leerse en una amplia entrevista en el blog Mujeres con Ciencia; del profesor Guillermo Quindós, que presentó la experiencia de la Revista Iberoamericana de Micología en lo que a publicaciones científicas de mujeres se refiere, y otras charlas sobre la mujer científica en Colombia o una conexión en directo con la coordinadora de Medicus Mundi en Guatemala, la doctora María Elisabeth Porras.







yo sólo pienso en la precariedad de los que, con suerte, tienen una beca para poder pasar mil horas en un laboratorio y que luego los echen a la calle o les digan que no pueden hacer los experimentos que necesitan porque no hay dinero. o en cómo se ha convertido en una carrera por publicar, sea lo que sea, en vez de hacer buena investigación de verdad. en que para poder trabajar en ésto es más fácil que te cojan en otros países que en aquel en el que te han formado, que aquí no se piensa que la ciencia sea una inversión, sino un sumidero de dinero sin beneficios (algo que se ha demostrado ampliamente que no es así). cuando pienso en la personificación de la ciencia sólo veo a un chaval de veintitantos metiendo más horas que nadie para que lo echen a la calle en cuanto puedan.eso es lo que pienso,
porque es la historia de muchos de nosotros.
Me gustaLe gusta a 1 persona